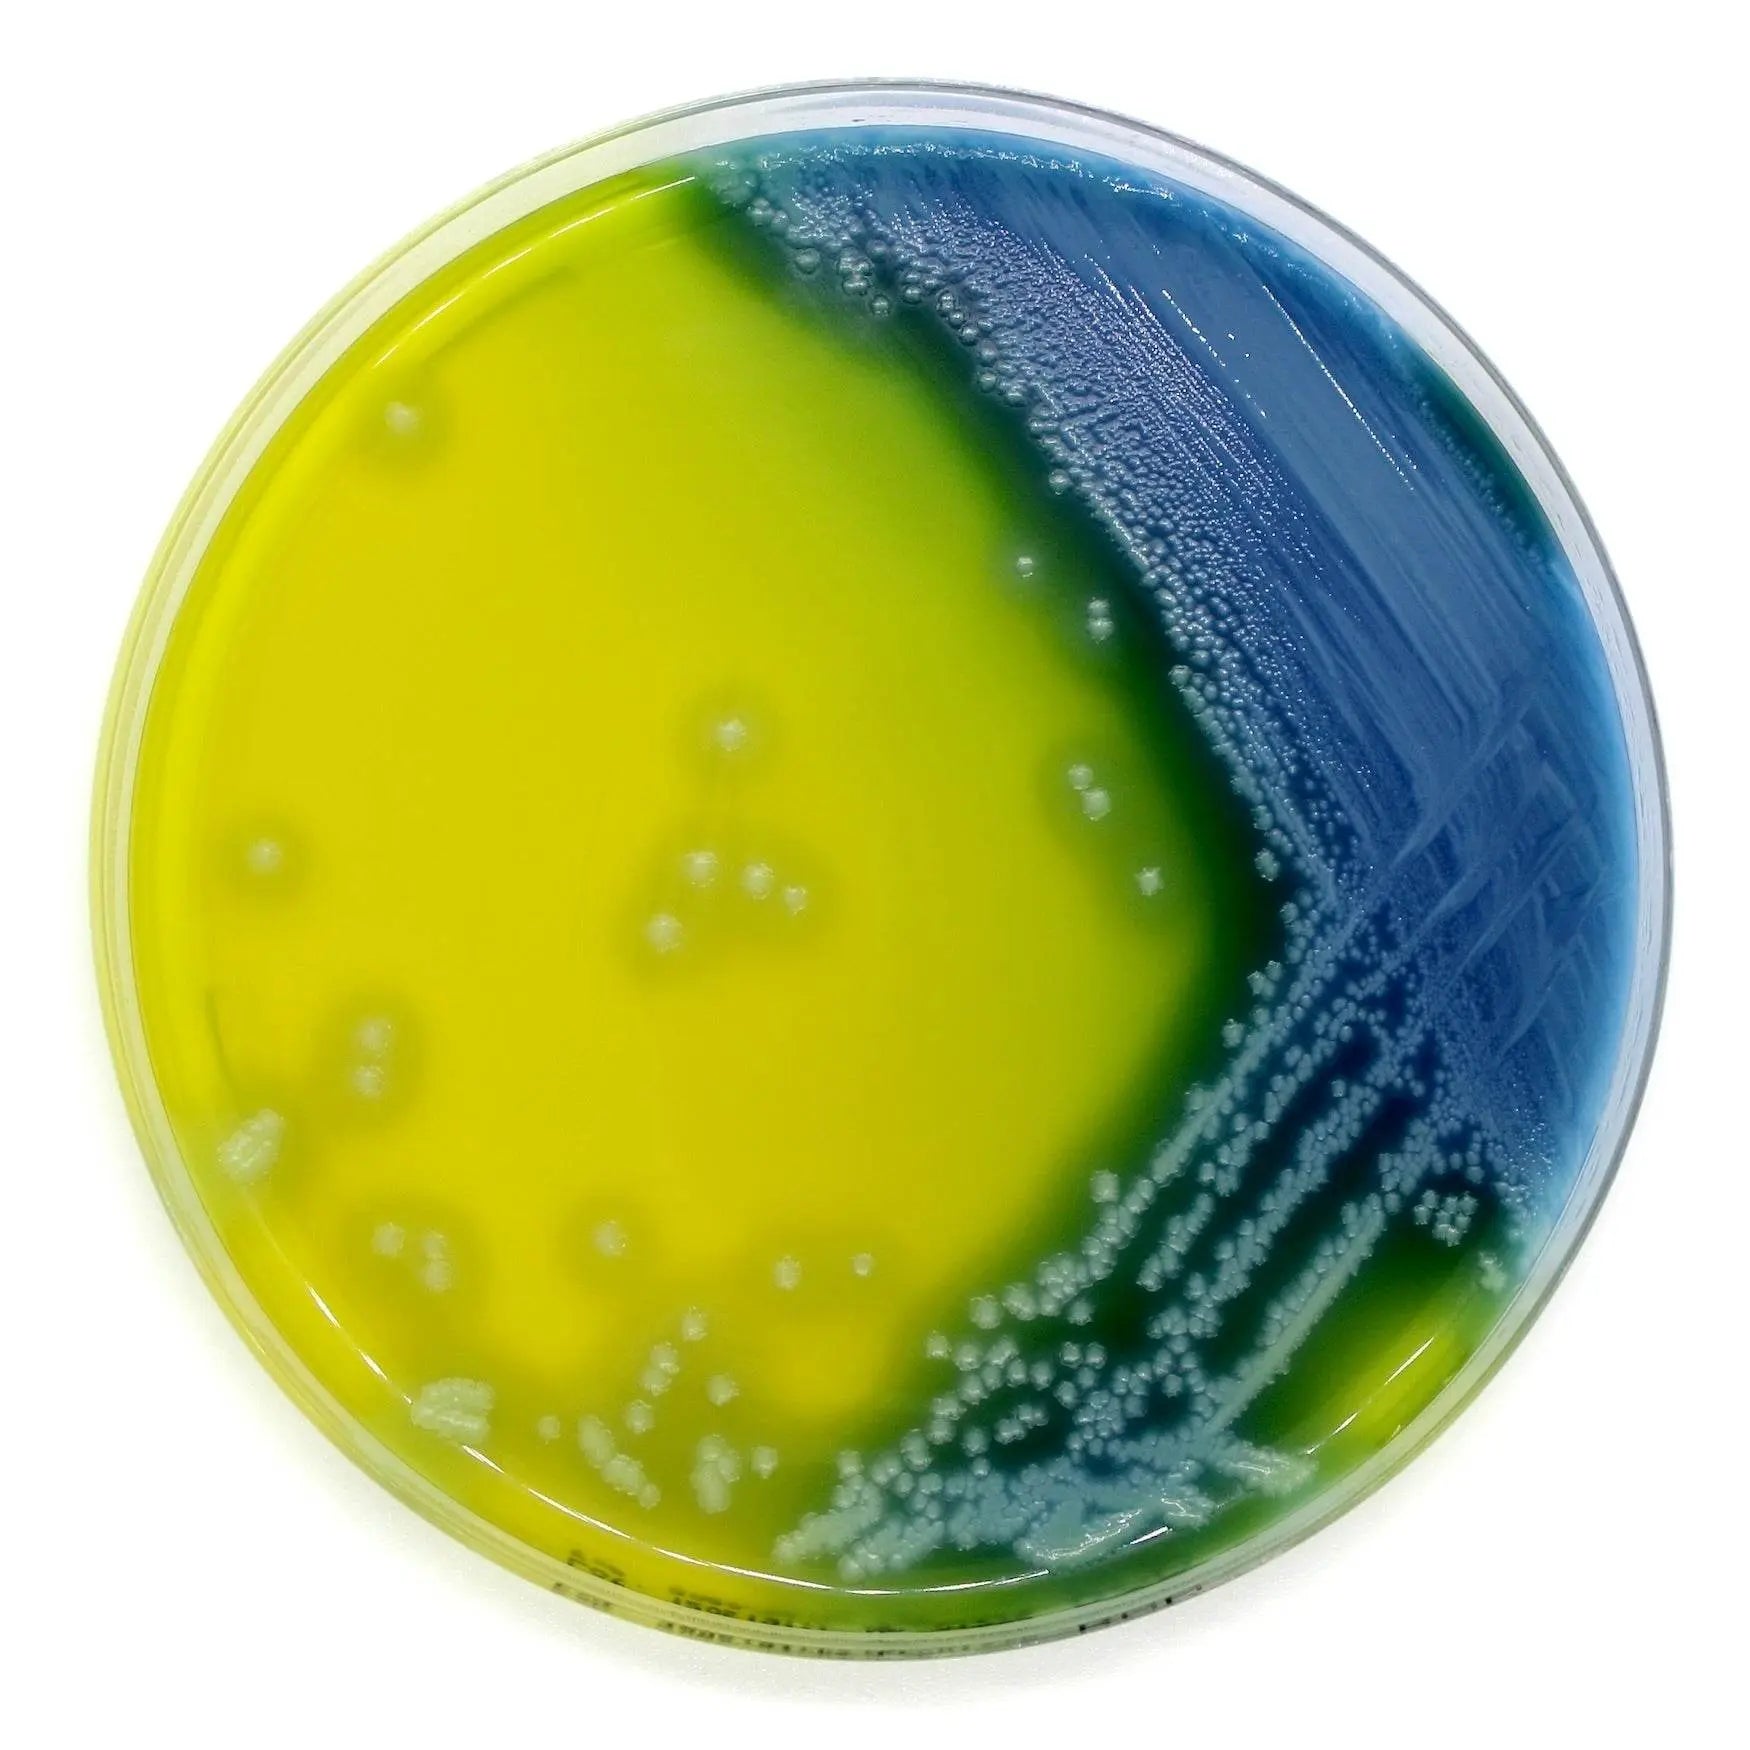
Bacillus cereus Agar (PEMBA) - Kormay Biomedicals store

Microbiology Media & Antimicrobial Susceptibility Testing (AST)
Shop Microbiology Media & AST products for clinical diagnostics, food safety, and research, including antibiotic discs and culture media.
Showing 73 - 108 of 996 products
Display
View

Liofilchem
Bacillus cereus Agar Base (MOSSEL) - For Microbiology Lab Testing
Sale priceFrom $185.00 CAD

Liofilchem
Bacillus cereus Agar Base (PEMBA) - For Microbiology Lab Testing
Sale priceFrom $161.00 CAD

Liofilchem
Baird Parker Agar + RPF Suppl. 90 mL - For Microbiology Lab Testing
Sale price$463.00 CAD
Filters (0)